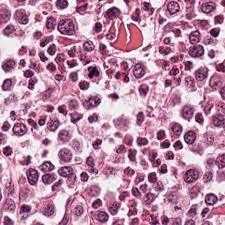
Digital Marketing Agency

The Right Marketing Touch Is Essential To Your Success
Multi Touch Marketing touch is just what your business needs to succeed.We are a full-service digital marketing agency serving businesses of all sizes.
Welcome back
Sign in to comment to your favorite stories, participate in your community and interact with your friends
or
LOG IN WITH FACEBOOKNo account? Create one
Recommended for you
Report this Content
This article has not been reviewed by Odyssey HQ and solely reflects the ideas and opinions of the creator.
Subscribe to our
Newsletter
Featured
AI music threatens creativity
The Soul of Sound: How AI Challenges Human Expression in Music
29 October 2025
530268
StableDiffusion
In an age where artificial intelligence can mimic the voice of Freddie Mercury or reimagine pop hits as synthwave ballads, a new frontier has emerged — one that blurs the line between innovation and erosion. While AI offers undeniable benefits in technical domains, its intrusion into creative arts, especially music, raises urgent questions. Not just about copyright, but about culture, education, and the very soul of artistic expression.
The Illusion of Creativity

AI-generated music is often marketed as “artistic” or “educational.” But what does it really teach?
- That style can be replicated without understanding.
- That emotion can be simulated without feeling.
- That effort can be bypassed with a prompt.
For young creators, this sets a dangerous precedent. Why learn to play guitar when an algorithm can do it faster? Why study harmony when AI can generate chord progressions in seconds? The risk isn’t just laziness — it’s the loss of depth, discipline, and the tactile joy of creation.
I have listened to several AI-generated music covers. My initial reaction was one of considerable impressiveness, particularly regarding the reimagining of classic pop hits in diverse genres with novel arrangements. Here is one good example a-ha — Take On Me
However, after engaging with several such Ai generated song covers, a sense of emotional detachment emerged, attributable to the perceived absence of human artistry and genuine sentiment, resulting in a technically flawless yet ultimately soulless auditory experience.
Copyright in Crisis

What does the copyright law say about AI generated music, especially in field of music covers. Who is liable for copyright in this case, AI developers, people who used AI to generate music or people who published it on music platforms?
Recent lawsuits show that the music industry is pushing back hard:
- Universal, Sony, and Warner sued AI music platforms Suno and Udio in 2024 for allegedly training their models on copyrighted songs without permission Ars Technica The Lyon Firm.
- They’re seeking up to $150,000 per infringed song, arguing that the AI outputs resemble famous tracks and voices (e.g., Mariah Carey, Michael Jackson).
- These lawsuits target the developers of the AI tools — but they raise broader questions:The legal gray area is training data. Courts haven’t yet ruled definitively on whether using copyrighted songs to train AI counts as infringement or fair use Sites at USC.
But who’s liable?
Role | Legal Risk | Why |
AI Developers | ✅ High | For training on copyrighted material without licenses. |
Users | ⚠️ Moderate | If they intentionally recreate protected works. |
Publishers/Platforms | ✅ High | For distributing infringing content. |
The grey area lies in training data. Courts haven’t yet ruled definitively on whether using copyrighted songs to train AI counts as infringement or fair use. Meanwhile, AI-generated works themselves aren’t eligible for copyright unless a human provides substantial creative input — leaving them in legal limbo.
The Educational Mirage

Some argue that AI music helps people learn genres, production styles, or vocal techniques. But this “education” often lacks context. It’s like learning to paint by watching a printer — technically impressive, but creatively hollow.
True musical education involves:
- Struggle and iteration: Learning through mistakes.
- Emotional connection: Expressing what words can’t.
- Cultural lineage: Understanding the roots of sound.
AI shortcuts bypass all of this. And in doing so, they risk flattening the rich terrain of human creativity into a sterile landscape of algorithmic mimicry.
Why This Fight Matters
This isn’t just about music. It’s about the future of art, storytelling, and human expression. If we allow machines to dominate creative spaces, we risk turning culture into content — optimized, monetized, and devoid of soul.
We must ask: Do we want a world where art is made by machines, or one where machines help humans make better art?
5 Key Takeaways
- AI-generated music blurs the line between innovation and erosion in the creative arts
- AI-generated music raises questions about copyright, culture, education, and artistic expression
- AI-generated music can replicate style without understanding, simulate emotion without feeling, and bypass effort with a prompt
- AI-generated music sets a dangerous precedent for young creators by potentially leading to a loss of depth, discipline, and joy of creation
Keep Reading...Show less
Entertainment
Every Girl Needs To Listen To 'She Used To Be Mine' By Sara Bareilles
These powerful lyrics remind us how much good is inside each of us and that sometimes we are too blinded by our imperfections to see the other side of the coin, to see all of that good.
01 April 2025
870295
The song was sent to me late in the middle of the night. I was still awake enough to plug in my headphones and listen to it immediately. I always did this when my best friend sent me songs, never wasting a moment. She had sent a message with this one too, telling me it reminded her so much of both of us and what we have each been through in the past couple of months.
"This song holds so much weight," she had told me. It means something. All the way across the world, living in Germany and training as an elite athlete, she had changed drastically over the past year. The same could be said of myself after leaving for college this July, and the majority of my thoughts lately have been constantly plagued with doubts about whether or not I made the right decision to move so far from everyone I loved. I pulled up the song on Apple Music that night and Sara Bareilles' voice encompassed me. Music has always had great power over me, something that could flip my emotions like a switch and speak a whole new meaning into my life. That was exactly what I experienced as these lyrics unfolded. Every word fit somewhere, spoke to who I was and who I am.
Sara Bareilles' song "She Used to be Mine" is about a young waitress with an abusive husband wondering how she got so disconnected from who she used to be. But here's what its lyrics mean to me, and what I feel they can speak to any girl who is struggling, anywhere.
This song hugely touches on change and what it's like to lose your former self. I'm sure at some point or another we have all, or someday will, experience a feeling similar to that: the feeling that you have lost who you used to be. For college students, this is so common because our entire lives are changed within the course of a year. New friends, new home, new schedule, new school. It's easy to sometimes look back on the person you were in high school and feel as though you no longer recognize her. Sara Bareilles tells us that if you miss the person you used to be, you must fight for them. We can see this gutsy resolve in her lyrics, "To fight just a little, to bring back that fire in her eyes, that's been gone but that used to be mine." These lines teach us to not give up so easily just because our lives have changed or our circumstances are difficult, Bareilles shows us that the girl you used to be is still inside of you, and you will find her again.
Once the song builds to the chorus, Bareilles attempts to show us how hard we all are on ourselves, and that for every flaw, there is a beautiful and perfect quality within us that makes up for that flaw.
"She's imperfect, but she tries.
She is good. but she lies.
... She is messy, but she's kind."
These powerful lyrics remind us how much good is inside each of us and that sometimes we are too blinded by our imperfections to see the other side of the coin, to see all of that good.
There is also a subtle message that speaks to traumas induced by broken relationships, a line empowering and uplifting any girl trudging through heartbreak. "For the girl that I knew...who'll get hurt, but who learns how to toughen up when she's bruised and gets used by a man who can't love." Those lyrics cut me to the heart when I first heard them because they reminded me so much of the girl that sent the song to me in the first place, who had just escaped an emotionally exhausting and degrading relationship. I thought about how strong she had to be to recover and be secure enough in herself to push through the heartache, despite being across the world from her family and utterly alone. These words were so powerful to her at that moment and can be powerful to so many other women who have felt "used" at any point in time.
Bareilles tells us that we are so much stronger than we think and that we all have a fire inside of us that will carry us through this season of hurting. It's a good reminder to hear and feel especially with Bareilles' powerful vocals carrying it across an empowering and raw chorus.
The power of music is boundless, and Bareilles proves that here. In the midst of the most trying stages of life, the most confusing seasons, and the moments when we don't even recognize the face in the mirror, I believe that a simple song could truly be something to soothe our souls and to maybe even remind us who we are.
Keep Reading...Show less
Entertainment
Why Your Astrological Sign May Not Match Your Personality
We are all more than just one sign.
31 March 2025
786119
What's your sign? It's one of the first questions some of us are asked when approached by someone in a bar, at a party or even when having lunch with some of our friends. Astrology, for centuries, has been one of the largest phenomenons out there. There's a reason why many magazines and newspapers have a horoscope page, and there's also a reason why almost every bookstore or library has a section dedicated completely to astrology. Many of us could just be curious about why some of us act differently than others and whom we will get along with best, and others may just want to see if their sign does, in fact, match their personality.
When talking to most of my friends about this topic, most of them would agree that they act like their sign. However, there are some who are more skeptical than others. Sometimes, I'll hear people say things like, “I’m not emotional,” or “I'm not introverted,” and "Why is it saying I am?" This is because we are not just made up of one single sign, but actually multiple signs (13 to be exact). Depending on where and when you were born, each of us have a different astrological chart, and each part of the chart represents a different aspect of life. The sign that part of the chart is under represents how we approach that aspect. To understand an astrological chart, though, it's best to understand what each sign means and stands for first.
Each sign, its principal symbol and what it stands for:
Aries: The Ram (March 21–April 19) — passion and competition
Taurus: The Bull (April 20–May 20) — stability and toughness
Gemini: The Twins (May 21–June 20) — communication and wit
Cancer: The Crab (June 21–July 22) — emotions and nurturing
Leo: The Lion (July 23–Aug. 22) — courage and friendliness
Virgo: The Maiden (Aug. 23–Sept. 22) — analysis and reliability
Libra: The Scales (Sept. 23–Oct. 22) — harmony and balance
Scorpio: The Scorpion (Oct. 23–Nov. 21) — intuitive and secretive
Sagittarius: The Centaur (Nov. 22–Dec. 21) — experience and honesty
Capricorn: The Goat (Dec. 22–Jan. 19) — ambitious and responsible
Aquarius: The Water Bearer (Jan. 20–Feb. 18) — politics and humanity
Pisces: The Fish (Feb. 19–March 20) — imagination and the mysterious
To better understand each astrological sign, as well as compatibility between all of them, there's something called sign elements and sign energy. Each sign is categorized in one of the four elements: fire, earth, air or water. Signs that are under the same element are typically ones that get along the best because they all have similar characteristics to one another. The 12 astrological signs can also be subdivided into two different categories — masculine and feminine signs. Fire and air signs are said to have more masculine energy, while water and earth signs are said to have more feminine energy. Signs with the same energy are supposed to get along the best, as well. To find out which signs get along the least with each other, spot the signs whose energies are directly opposite from one another in the chart below:
Elements + masculine and feminine signs
Feminine Energy
Earth: Capricorn, Taurus, Virgo
Water: Scorpio, Pisces, Cancer
Masculine Energy
Air: Gemini, Libra, Aquarius
Fire: Aries, Leo, Sagittarius
The parts of an astrological chart.
As I mentioned earlier, we are not made up of just one sign. Our personalities are dictated by 13 unique signs. The first of the 13 is known as your sun sign, and it's the main sign we know ourselves as. The 12 other “houses” in the chart, all represent a different aspect of life. The rest of the items in your chart matter almost as much, if not more, than your sun sign. For example, a person can have Virgo as their sun sign, but if nothing else in their chart is Virgo or even a sign similar to Virgo, the person may not act too much like a Virgo. What makes up your chart and where it's placed can make your sun sign not make sense. Most Capricorns are known to be quiet people, but if a person has a talkative, outgoing sign like Gemini ruling their third house, the House of Communication, they might not be as quiet or as introverted. Below are the 13 parts of an astrological makeup and what each part represents:
Your sun sign — your general approach towards life
First House — actions/temperament
Second House — personal values/money
Third House — communication/thinking
Fourth House — emotions/settling down
Fifth House — expression/confidence
Sixth House — health/preservation
Seventh House — partnerships/love
Eighth House — change/intimacy
Ninth House — philosophy/spirituality
10th House — career/reputation
11th House — visions/Insight on society
12th House — imaginations/tolerance
Although astrology is cool and can be fun, it is also best to take everything you read with a grain of salt.
Keep Reading...Show less
Entertainment
20 Song Lyrics To Put A Spring Into Your Instagram Captions
"On an island in the sun, We'll be playing and having fun"
31 March 2025
777029
Photo by Spencer Imbrock on Unsplash
Whenever I post a picture to Instagram, it takes me so long to come up with a caption. I want to be funny, clever, cute and direct all at the same time. It can be frustrating! So I just look for some online. I really like to find a song lyric that goes with my picture, I just feel like it gives the picture a certain vibe.
Here's a list of song lyrics that can go with any picture you want to post!
"Life in Color" - OneRepublic
"This is life in color, Today feels like no other. And the darkest grays, The sun bursts, cloud breaks, This is life in color."
"Here comes the sun" - The Beatles
"Little darling, it's been a long cold lonely winter. Little darling, it feels like years since it's been here. Here comes the sun, Here comes the sun, and I say, It's all right."
"Why don't you love me" - Beyonce
“There’s nothing not to love about me I’m lovely."
"Hotline Bling" - Drake
"Running out of pages in your passport"
"New Romantics" - Taylor Swift
"Heartbreak is the national anthem"
"How He Loves" -David Crowder Band
"Loves like a hurricane, I am a tree bending beneath, the weight of His wind and mercy"
"Call it what you want" - Taylor Swift
"All my flowers grew back as thorns. Windows boarded up after the storm. He built a fire just to keep me warm."
"Island in the sun" - Weezer
"On an island in the sun, We'll be playing and having fun, And it makes me feel so fine, I can't control my brain. We'll run away together. We'll spend some time forever."
"Ride" -twenty one pilots
"I'm falling so I'm taking my time on the ride."
"Perfect" - One Direction
"And if you like midnight driving with the windows down, then baby I'm perfect for you"
"Honest" -The Neighbourhood
"I hope you find a way to be yourself someday"
"God's Plan" - Drake
"I only love my bed and my momma, I'm sorry"
"This town" - Niall Horan
"If the whole world was watching, I'd still dance with you"
"Bless the broken road" -Rascal Flatts
" God blessed the broken road, that led me straight to you"
"Trust in you" -Lauren Daigle
"When You don't move the mountains, I'm needing You to move. When You don't give the answers, As I cry out to You. I will trust, I will trust, I will trust in You"
"Livin' on a prayer" -Bon Jovi
"Take my hand and we'll make it I swear"
"Youth" -Troye Sivan
"Trippin' on skies, sippin' waterfalls. My youth, my youth is yours. Runaway now and forevermore."
"Something in the water" - Carrie Underwood
"And now I'm changed, And now I'm stronger. There must be something in the water. Oh, there must be something in the water."
"The only exception" - Paramore
"You are, the only exception"
"I walk the line" - Johnny Cash
"I keep a close watch on this heart of mine"
Enjoy this GIF of a doggo living his best life
Keep Reading...Show less
Relationships
The Importance Of Being A Good Person
An open letter to the good-hearted people.
28 March 2025
1088148
WP content
Being a good person does not depend on your religion or status in life, your race or skin color, political views or culture. It depends on how good you treat others.
We are all born to do something great. Whether that be to grow up and become a doctor and save the lives of thousands of people, run a marathon, win the Noble Peace Prize, or be the greatest mother or father for your own future children one day. Regardless, we are all born with a purpose. But in between birth and death lies a path that life paves for us; a path that we must fill with something that gives our lives meaning.
However, there are times where the obstacles of life seem to get the best of us and we often let it go to heart. And by obstacles, I mean people who often take advantage of mistreating others. But, instead of taking each and every negative thing or action that happens to you as a personal attack on your character, remember one thing: you're a good person.
I know it sounds corny, but it's true. It's so important to remember that you're a good person and you don't deserve to be treated or feel like otherwise. The biggest problem that people often face is that struggle of others taking advantage of you and your good heart. But, don't let this get the best of you. Instead, let it be a lesson for you to realize that not everyone will truly appreciate your kindness and those are the people whom you should eliminate from your life.
No matter how many people try to tell you otherwise, never change who you are for anyone. Keep doing things for other people out of the goodness of your heart, not for the sole purpose to please others. It's so important to stay true to who you are in order to serve as a role model for those who look up to you. Even though you may not realize it, you serve a huge significance in someone else's life where they feel as if they have been influenced by the person you are to the point where he or she only aspires to be as good of a person as you.
I also know there are times where being a good person seems like the worst possible thing; almost as if it's a trait that works completely against you. There are times where people walk all over you, or not include you in their plans, or maybe act like you don't even exist because you're just convenient to them when they need you. Those are the worst kinds of people. But you need to remember something, you matter. You treat people the way you would want to be treated and that is one of the biggest indicators that you are human in the sense that you see the goodness in others as well.
Being a good person is a lot more than what others seem to give you credit for. People don't understand that those like us whom have good hearts and are just always there for other people, have to deal with a lot of negativity because people tend to associate kindness with weakness. But actually, it's the complete opposite. When you're a good person, you are the strongest type of person there is. You are the one who people confide in whenever they need comfort or advice. You are the one who your friends come to whenever they have good or bad news.
At the end of the day, you are the one who are the one people will always be thankful for because their lives wouldn't be the same without you.
Keep Reading...Show less